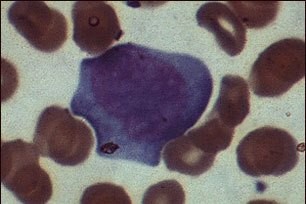

Мононуклеоз
Содержание
Когда необходимо обратиться к врачу.
Общая информация
Мононуклеоз - это вирусная инфекция, характеризующаяся возникновением лихорадки, ангины и увеличением лимфатических узлов, особенно в области шеи.
Причины
Мононуклеоз, или моно, часто распространяется через слюну при тесном контакте. Заболевание известно как "болезнь поцелуев" и может возникнуть в любом возрасте, но чаще оно встречается среди лиц 15-17 лет.
Мононуклеоз, как правило, связан с вирусом Эпштейна-Барра, но также он может быть вызван и другими микрорганизмами, такими как цитомегаловирус (ЦМВ).
Эта, так называемая, "Ложная клетка", встречающаяся при инфекционном мононуклеозе, является типичным лимфоцитом, инфицированным ВЭБ (вирусом Эпштейна-Барра) или ЦМВ (цитомегаловирусом). При мононуклеозе можно выделить три морфологических типа лимфоцитов. Этот лимфоцит относится ко II типу клеток.
Симптомы
Мононуклеоз начинается медленно с симптомов усталости, общего недомогания, головной боли и боли в горле. Боль в горле постепенно прогрессирует. Миндалины отекают и покрываются беловато-желтым налетом. В большинстве случаев возникает увеличение шейных лимфатических узлов, постепенно они становятся припухшими и болезненными.
Заболевание характеризуется появлением кореподобной сыпи. Ее появление более вероятно при приеме антибиотиков, таких как ампициллин или амоксициллин для лечения воспаления горла. (Антибиотики не следует назначать без положительного результата обследования на стрептококк).

Увеличение лимфатических узлов, боль в горле, усталость и головная боль являются распространенными симптомами мононуклеоза, вызванного вирусом Эпштейна-Барра. Как правило, у большинства пациентов заболевание проходит самостоятельно в течение 4-6 недель, даже при отсутствии лечения.
К симптомам мононуклеоза относятся:
- Сонливость
- Лихорадка
- Чувство дискомфорта, беспокойство или общее недомогание
- Потеря аппетита
- Боль или скованность мышц
- Сыпь
- Боль в горле
- Увеличение лимфатических узлов, особенно в области шеи и подмышек
- Увеличение селезенки
Симптомы, встречающиеся реже:
- Боль в груди
- Кашель
- Усталость
- Головная боль
- Крапивница
- Желтуха (желтушная окраска кожи)
- Ригидность затылочных мышц
- Носовое кровотечение
- Учащение сердечного ритма
- Светобоязнь
- Одышка
Диагностика
Врач или медицинская сестра проведут осмотр, в ходе которого могут быть выявлены:
- Увеличенные передние и задние шейные лимфатические узлы
- Припухшие миндалины, покрытые беловато-желтым налетом
- Увеличенная печень или селезенка
- Сыпь
К необходимым анализам крови относятся:
- Количество лейкоцитов - будет выше, чем обычно
- Анализ на мононуклеоз - будет положительным при наличии заболевания.
- Определение титра антител – помогает дифференцировать текущую и перенесенную инфекцию
Лечение
Целью лечения является облегчение симптомов заболевания. При тяжелом течении болезни могут быть назначены глюкокортикостероиды (преднизолон).
Противовирусные препараты, такие как ацикловир практически не эффективны.
Советы по облегчению типичных симптомов болезни:
- Пейте много жидкости.
- Для облегчения боли в горле полощите его теплой соленой водой.
- Больше отдыхайте.
- При наличии лихорадки и боли примите ацетаминофен или ибупрофен
Также вам следует избегать контактных видов спорта для предотвращения разрыва селезенки.
Прогноз
Лихорадка обычно проходит через 10 дней, а увеличенные лимфатические узлы и селезенка возвращаются к своим обычным размерам в течение 4 недель. Усталость проходит в течение нескольких недель, но может сохраняться в течение 2-3 месяцев.
Возможные осложнения
К осложнениям мононуклеоза относятся:
- Бактериальная инфекция горла
- Гемолитическая анемия
- Гепатит с желтухой (чаще встречается у пациентов старше 35 лет)
- Воспаление яичек (орхит)
- В редких случаях могут возникнуть неврологические нарушения, такие как:
- Синдром Гийена-Барре
- Менингит
- Судороги
- Временный паралич лицевого нерва (паралич Белла)
- Неконтролируемые движения (атаксия)
- Разрыв селезенки (редко; необходимо избегать давления на селезенку)
- Сыпь (акродерматит детства)
При ослаблении иммунной системы не исключен летальный исход.
Когда необходимо обратиться к врачу
Начальные симптомы мононуклеоза схожи с симптомами типичного вирусного заболевания. Необходимо обратиться к врачу, если заболевание длится дольше 10 дней или имеются следующие симптомы:
- Боль в животе
- Дыхательная недостаточность
- Постоянно высокая температура (более 380С)
- Сильная головная боль
- Сильная боль в горле или увеличение миндалин
- Слабость в руках или ногах
- Желтушное окрашивание склер и кожи
Незамедлительно обратитесь в службу оказания экстренной медицинской помощи по телефону 103 при наличии у вас следующих симптомов:
- Внезапная острая, сильная боль в животе
- Значительное затруднение глотания или дыхания
- Напряженность затылочных мышц или сильная слабость
Профилактика
Лица с мононуклеозом могут быть заразными при наличии симптомов заболевания и в течение нескольких месяцев после этого. Длительность заразного периода может варьировать. Вне организма вирус может жить нескольких часов. Избегайте поцелуев и совместного использования посуды, если вы или кто-то из вашего окружения болен мононуклеозом.
Синонимы
Моно; Болезнь поцелуев
